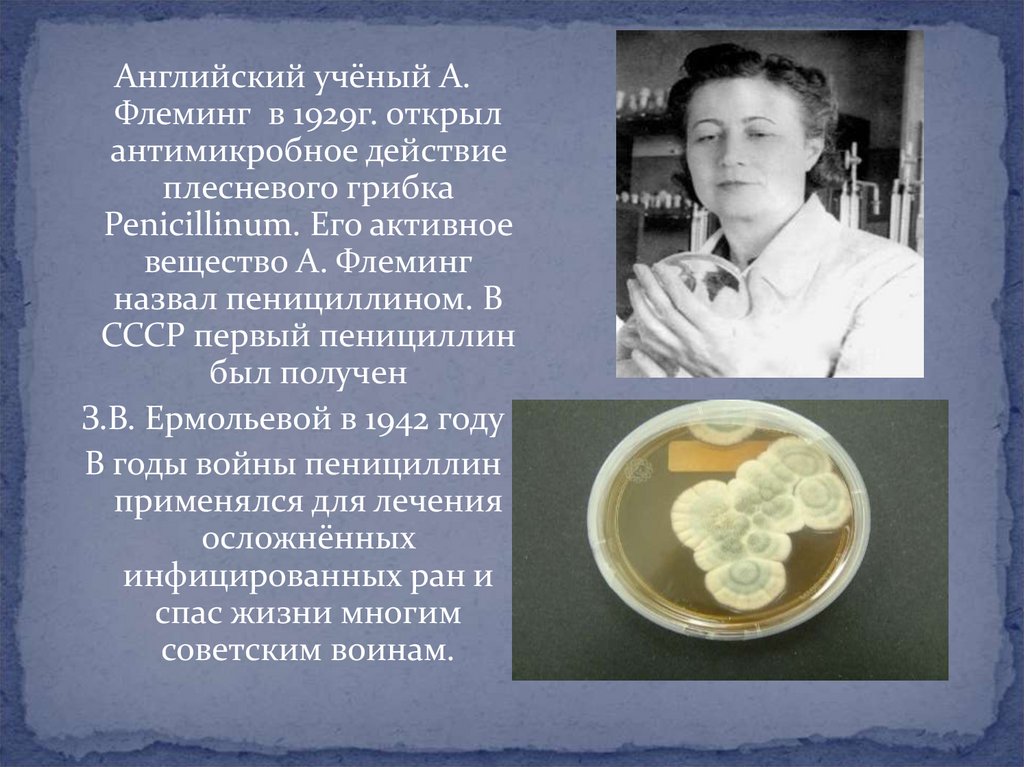

Similar presentations:
Открытия биологических наук в годы ВОВ
1. Открытия биологических наук в годы ВОВ
2.
Ученые - фронтуВ годы войны, когда все силы науки были сосредоточены
на самых актуальных вопросах помощи фронту,
биологические учреждения АН СССР направили усилия
своих ученых на то, чтобы дать стране максимальное
количество сельскохозяйственной продукции. Научную
разработку проблем сельскохозяйственного
производства осуществляла Всесоюзная академия
сельскохозяйственных наук имени В.И.Ленина
(ВАСХНИЛ)
Ученые ВАСХНИЛ разрабатывали применительно к
особенностям отдельных районов Урала, Сибири,
Казахстана, Средней Азии эффективные приемы
семеноводства и агротехники с целью получения в этих
районах высоких урожаев зерновых, масличных,
кормовых культур, сахарной свеклы, картофеля.
3. Здравоохранение в годы ВОВ
Большой объем работы былпроделан главным
эпидемиологом и
инфекционистом Красной
армии И.Д. Иониным.
Стройная система
противоэпидемических
мероприятий, санитарно –
гигиеническое обеспечение
Красной Армии привели к
небывалому в истории войн
результату – в период
Великой Отечественной
войны в советских войсках не
было эпидемий
4. Помощь науки
На фронте и в тылу широкое распространениеполучил метод местного обезболивания,
разработанный А.В.Вишневским - он применялся в
85-90% случаев.
5.
Английский учёный А.Флеминг в 1929г. открыл
антимикробное действие
плесневого грибка
Penicillinum. Его активное
вещество А. Флеминг
назвал пенициллином. В
СССР первый пенициллин
был получен
З.В. Ермольевой в 1942 году
В годы войны пенициллин
применялся для лечения
осложнённых
инфицированных ран и
спас жизни многим
советским воинам.
6.
«Рождение» пенициллина послужило импульсом длясоздания других антибиотиков. Так, советский
биолог Георгий Францевич Гаузе вместе с женой –
ученым-химиком Марией Георгиевной
Бражниковой – в годы войны синтезировал первый
оригинальный советский антибиотик –
грамицидин.
7.
Благодаряпротивомикробному
действию
антибиотиков во время
войны и в мирное
время были спасены
десятки тысяч жизней
при таких опасных
заболеваниях, как
газовая гангрена,
столбняк, менингит,
септические (гнойные)
инфекции.
8.
Ученые-химики создавалилекарственные препараты,
необходимые для лечения
раненых. Так, полимер
винилбутилового спирта,
полученный М. Ф.
Шостаковским, — густая
вязкая жидкость —
оказался хорошим
средством для заживления
ран, он использовался в
госпиталях под названием «бальзам Шостаковского».
9.
Учёные Ленинграда разработали и изготовили более60 новых лечебных препаратов, в 1944 году освоили
метод переливания плазмы, создали новые
растворы для консервации крови.
10.
Враг, напавший на нашу Родину, был жесток ибесчеловечен. И то, что фашистское командование не
решилось использовать в войне бактериологическое и
химическое оружие, является заслугой наших советских
ученых, разработавших средства противохимической и
противобиологической обороны, которые находились в
боевой готовности на протяжении всех военных лет.
Фронт и тыл были надежно защищены.
11.
В годы войны не хватало ваты иперевязочных материалов.
Врач Новотельнов догадался
использовать вместо ваты мох
сфагнум. Мох заменил и йод:
содержащееся в нем фенольное
соединение - сфагнол, подобное
карболовой кислоте, обладает
дезинфицирующими свойствами, и в
ранах не развивается гнойная
инфекция. По абсорбционным
свойствам, по способности впитывать
воду и кровь сфагнум не уступает вате.
Исследователи показали, что одна
весовая часть сфагнума может
впитывать до 25 весовых частей воды.
12.
Проблема свертывания крови имела огромнуюважность в годы войны. Б.А. Кудряшов по заданию
правительства разработал метод промышленного
производства препарата «тромбин» для остановки
кровотечений, что спасло жизни сотен тысяч
людей
13.
Ученица КудряшоваГ.В. Андреенко
разработала и
внедрила в
производство
водорастворимый
витамин К, который
способствует
остановке
кровотечений и
заживлению ран
14.
Крушинский Л. В. занимался подготовкой собак дляпротивотанковой обороны, минорозыскной
службы и перевозки раненых . В период активных
действий 10-й армии за 4 месяца 1944 года с
помощью собак было вывезено 13500 тяжело
раненных бойцов и доставлено 300 тонн
боеприпасов.
15.
Д.А. Транковский,специалист в области
анатомии растений, по
заданию военных
проводил биологические
исследования древесных
материалов для
авиапромышленности.
Орнитологи В.Ф. Ларионов
и Е.А. Светозаров по
заданию армии
выполняли работы в
области военного
голубеводства.
16.
Великая отечественная война явилась серьезнойпроверкой творческих сил нашей науки. Этот
трудный экзамен она с честью выдержала. Она
продемонстрировала перед всем миром свою силу и
способность в короткие сроки использовать научные
достижения не только в мирных, но и в оборонных
целях. Большой вклад в дело победы внесли
биологи. Чем дальше по времени уходят годы войны,
тем ярче становятся воспоминания о тех людях,
которые ценой своей жизни, боролись на фронте и в
тылу за честь и независимость нашей Родины.
17.
Использованная литература:1. А.А.Пархоменко, А.С.Федоров. Сражающаяся наука. – М: Знание, 1990
2. В.С.Чесноков. Никто не забыт и ничто не забыто. Биология в школе, 2005 №2.
3. Ланге, К. Физиологические науки в СССР. Становление. Развитие.
Перспективы / К.Ланге. - Л.: Наука, 1988. - 479 с.
4. Широков, Г.А. Научные изыскания ученых сельскохозяйственной науки в
годы Великой Отечественной войны. 1941-1945 гг. / Г.А.Широков. - М.: СамГУ. 2007. - №5/3. - С.55.
5.
http://go.mail.ru/redir?q=картинки%20достижения%20биологической%20науки
%20%20

history
history








